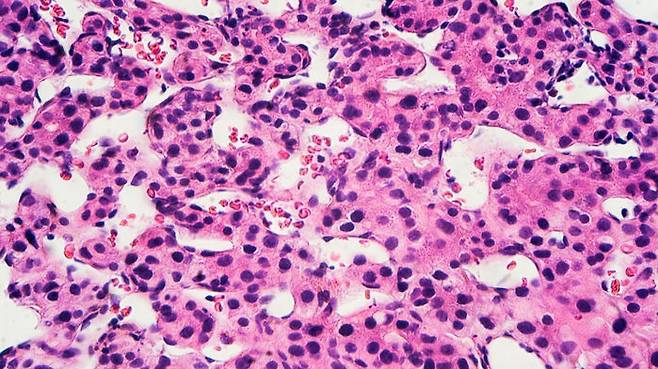

"감염 실태 모르는 D형 간염, B형보다 훨씬 더 위험하다"
전체 맥락을 이해하기 위해서는 본문 보기를 권장합니다.
D형 간염 바이러스는 B형 바이러스 보유자한테만 추가로 감염됩니다.
B형과 D형의 동시 감염이 진행되는 것입니다.
실제로 D형 간염 바이러스 보유자가 간세포암(hepatocellular carcinoma)에 걸릴 위험이, B형 바이러스만 가진 사람의 최고 3배에 달한다는 연구 결과가 나왔습니다.
그러나 B형 간염 바이러스 감염자 가운데 어느 정도가 D형에 중복 감염돼 있는지는 확실하지 않습니다.
이 글자크기로 변경됩니다.
(예시) 가장 빠른 뉴스가 있고 다양한 정보, 쌍방향 소통이 숨쉬는 다음뉴스를 만나보세요. 다음뉴스는 국내외 주요이슈와 실시간 속보, 문화생활 및 다양한 분야의 뉴스를 입체적으로 전달하고 있습니다.
간염을 일으키는 바이러스 가운데 일반인에게 가장 생소한 건 D형 바이러스입니다.
D형 간염 바이러스는 B형 바이러스 보유자한테만 추가로 감염됩니다.
B형과 D형의 동시 감염이 진행되는 것입니다.
사실 D형 간염은 가장 위험한 바이러스성 만성 간염 가운데 하나입니다.
D형 간염은 간암이나 간경변 같은 회복 불가능한 간 질환을 유발할 가능성이 큽니다.
실제로 D형 간염 바이러스 보유자가 간세포암(hepatocellular carcinoma)에 걸릴 위험이, B형 바이러스만 가진 사람의 최고 3배에 달한다는 연구 결과가 나왔습니다.
스위스 제네바대(UNIGE)와 제네바 대학병원(HUG) 과학자들이 체계적인 문헌 고찰과 데이터 메타 분석(meta-analysis)을 통해 밝혀낸 것입니다.
관련 논문은 '유럽 간 학회(EASL)'가 발행하는 '저널 오브 헤파톨로지(Journal of Hepatology)'에 최근 실렸습니다.
간염 바이러스는 A형부터 E형까지 다섯 종류가 있습니다.
A형과 E형은 급성 감염증을 유발하긴 하지만 대부분 일과성 증상에 그칩니다.
그러나 B·C·D 3개 유형은 만성 간염으로 진행해 짧으면 수개월, 길면 몇 년 뒤에 간 기능 이상을 가져옵니다.
2011년 치료법이 개발된 C형 간염은 현재도 잘 치료되는 편입니다.
그런데 B형과 D형은 여전히 관리하기 어려운 질환에 속합니다.
B형과 D형이 동시에 감염하면 간경변의 진행이 빨라진다는 건 이미 학계에 보고됐습니다.
이번 연구는 B형과 D형의 동시 감염이, 간세포암의 진행을 어느 정도 가속하는지 밝히는 데 초점을 맞췄습니다.
간세포암은 매우 공격적이고 치명률도 높은 암으로 분류됩니다.
연구팀은 모두 합쳐 10만 명 이상의 환자를 대상으로 진행된 93건의 선행연구 데이터를 정밀히 재검토해 결론에 도달했습니다.
세계보건기구(WHO)에 따르면 전 세계의 B형 간염 바이러스 감염자는 수억 명에 달할 것으로 추정됩니다.
그러나 B형 간염 바이러스 감염자 가운데 어느 정도가 D형에 중복 감염돼 있는지는 확실하지 않습니다.
논문의 제1 저자인 둘체 알파이아테 연구원은 "D형 간염 바이러스 보유자를 1천500만 내지 2천만 명으로 추정한 것도 있지만 어떤 연구에선 6천만까지 보기도 한다"라면서 "6천만 명이면 에이즈 바이러스(HIV) 보유자 수의 거의 두 배에 달하는 것"이라고 지적했습니다.
요즘엔 간경변 증상이 있는 20대 중후반의 젊은 층에서도 D형 간염의 감염 사례가 보고되는데도 아직 효과적인 치료법은 개발되지 않았습니다.
연구팀은 "B형 감염자를 대상으로 하는 D형 감염 검사를 확대해야 하며, 효과적인 항바이러스 치료제 개발도 시급하다"라고 강조했습니다.
(사진=제네바대 제공, 연합뉴스)
유영규 기자ykyou@sbs.co.kr
Copyright © Copyright ⓒ SBS. All rights reserved. 무단 전재, 재배포 및 AI학습 이용 금지
- [영상] "평생 친모에 버림받은 상처"..구하라 오빠의 눈물
- "월세 대신 몸으로.." 빈곤층 여성 노리는 집주인들
- "서랍에 돈다발, 20년간 장부 없었다" 나눔의집 직원 폭로
- '강원래 아내' 김송 "상간녀 절대 용서못해"..여다경에 분노
- 건장했던 사나이, 확진 뒤 '뼈만 앙상'..치료 전후 공개
- '아베 총애' 받던 그 남자, 일본 발칵 뒤집어놨다
- '성추행 추락' 오거돈, 몰래 출석.."비공개 소환" 강력 요구
- "재난지원금으로 고기 좀 뜯어보자!" 판매 폭발했다
- "최신종, 언젠가 사람 죽일 수 있다 생각" 쏟아진 증언
- [현장] 무덤 옆 무덤 '다닥다닥'..공포의 코로나